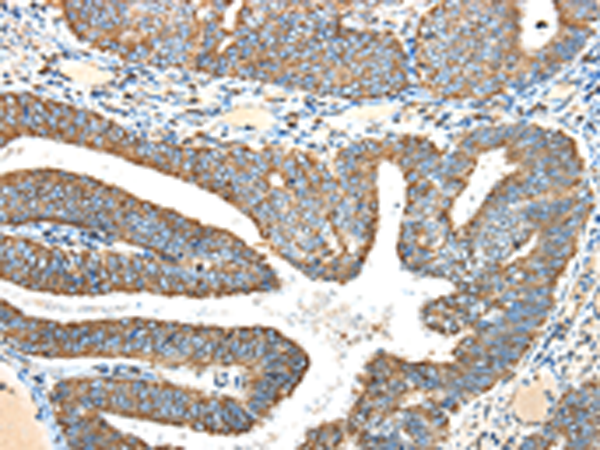
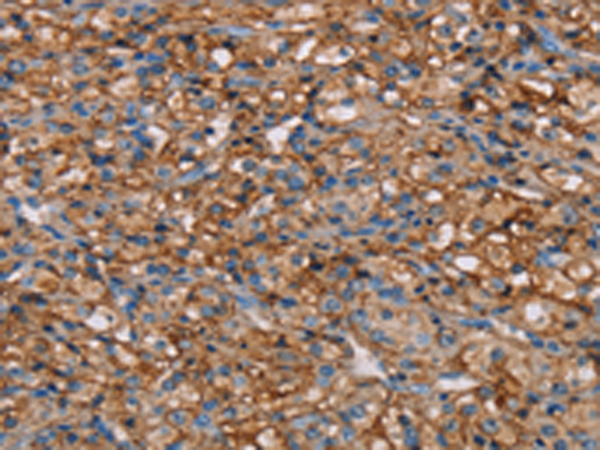

-
分类: 科研抗体货号: P08568别名: CSX; CSX1; VSD3; CHNG5; HLHS2; NKX2E; NKX2.5; NKX4-1应用: IHC反应种属: Human, Mouse, Rat
-
分类: 科研抗体货号: P08586别名: NOE3; NOELIN3; OPTIMEDIN应用: WB反应种属: Human, Mouse, Rat
-
分类: 科研抗体货号: P08548别名: B13; NUFM; UQOR13; CI-13kB; CI-13KD-B应用: WB,IHC反应种属: Human, Mouse
-
分类: 科研抗体货号: P08567别名:应用: WB,IHC反应种属: Human, Mouse, Rat
-
分类: 科研抗体货号: P08585别名: CT134; ODF84; ODF2/1; ODF2/2应用: WB,IHC反应种属: Human, Mouse, Rat
-
分类: 科研抗体货号: P08547别名: CGI65; CIA30; CGI-65应用: IHC反应种属: Human, Mouse
-
分类: 科研抗体货号: P08564别名: RSP5; NEDD4-2; NEDD4.2; hNEDD4-2应用: IHC反应种属: Human, Mouse
-
分类: 科研抗体货号: P08584别名: OCIA; ASRIJ; TPA018应用: WB反应种属: Human, Mouse, Rat
-
分类: 科研抗体货号: P08546别名: MWFE; ZNF183; CI-MWFE; MC1DN12应用: WB,IHC反应种属: Human, Mouse, Rat
-
分类: 科研抗体货号: P08563别名: PPR3; PRR3; CD113; PVRL3; PVRR3; CDW113; NECTIN-3应用: WB,IHC反应种属: Human, Mouse

鄂公网安备42018502007531号
鄂公网安备42018502007531号

